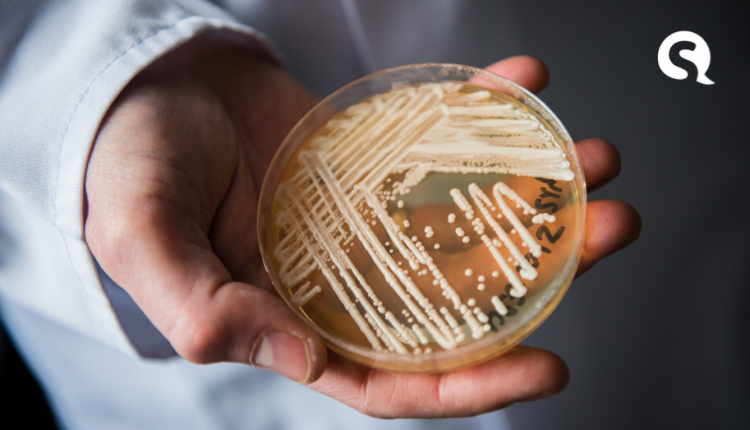

Anvisa emite alerta sobre primeiro caso de ‘superfungo’ fatal no Brasil
A Agência Nacional de Vigilância Sanitária(Anvisa) emitiu, na última segunda-feira (7), um alerta sobre o primeiro caso positivo no Brasil de um ‘superfungo’ chamado “Candida auris“. O fungo é resistente a medicamentos e é responsável por infecções hospitalares.
De acordo com a Anvisa, o Candida auris (C. auris) “é um fungo emergente que representa uma séria ameaça à saúde pública”, diz em seu alerta. O alerta da Anvisa explica também que a infecção pelo fungo é resistente a medicamentos e pode matar. No planeta, estima-se que infecções fúngicas invasivas de C. auris tenham levado à morte entre 30% e 60% dos pacientes.
O fungo foi identificado segundo a Anvisa em uma amostra de ponta de cateter de paciente internado em UTI adulto em hospital do estado da Bahia. Logo depois da sua identificação, a amostra contendo o fungo foi estudada pelos Laboratórios Central de Saúde Pública Profº Gonçalo Moniz (Lacen-BA), em Salvador e do Hospital das Clínicas da Faculdade de Medicina da Universidade de São Paulo.
Amostra passará por novos testes
A Anvisa disse que a amostra ainda passará por novos testes. O novo estudo vai verificar o perfil de sensibilidade e resistência e sequenciamento genético do microrganismo (padrão-ouro) até a confirmação oficial do caso. Enquanto o resultado dos novos testes não sai, a Anvisa pede o reforço da vigilância laboratorial do fungo em todos os serviços de saúde do Brasil, entre outras medidas de controle e prevenção para evitar um surto.
Fungo identificado pela 1ª vez no Japão
O fungo foi identificado pela primeira vez em 2009 no canal auditivo de uma paciente no Japão. Desde então, houve casos identificados em países como Índia, África do Sul, Venezuela, Colômbia, Estados Unidos, Israel, Paquistão, Quênia, Kuwait, Reino Unido e Espanha.
Nem todos os hospitais identificam o C. auris da mesma maneira. Às vezes, o fungo é confundido com outras infecções fúngicas, como a candidíase comum. Além disso, o C. auris é muito resistente e pode sobreviver em superfícies por um longo tempo.
Resistência a drogas
A resistência aos antifúngicos comuns, como o fluconazol, foi identificada na maioria das cepas de C. auris encontradas em pacientes internados nos hospitais. Sendo assim, essas drogas não funcionam para combater o fungo. Por causa disso, medicações fungicidas menos comuns têm sido utilizadas para cuidar das infecções, porém o C. auris também desenvolveu resistência a elas.
“Há registro de resistência à azólicos, equinocandinas e até polienos, como a anfotericina B. Isso significa que o fungo pode ser resistente às três principais classes de drogas disponíveis para tratar infecções fúngicas sistêmicas”, afirmou o epidemiologista e microbiologista Alison Chaves, no Twitter.
Análises de DNA indicam também que genes de resistência antifúngica presentes no C. auris têm passado para outras espécies de fungo, como a Candida albicans (C. albicans), um dos principais causadores da candidíase (doença comum que pode afetar a pele, as unhas e órgãos genitais, e é relativamente fácil de tratar).